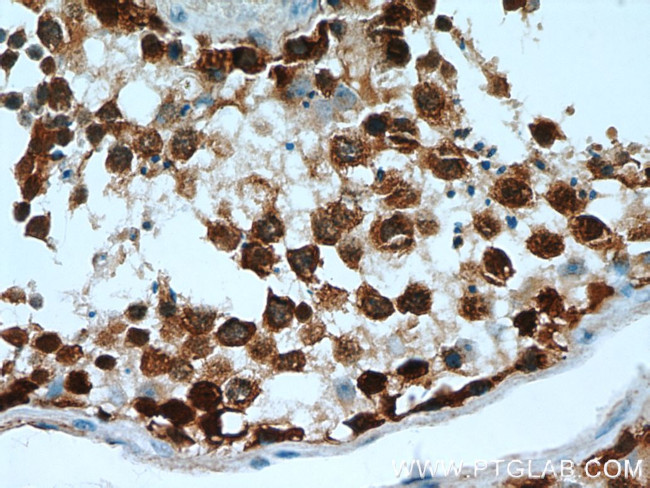
TSPY3 Antibody in Immunohistochemistry (Paraffin) (IHC (P))
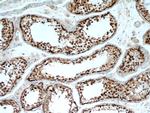
TSPY3 Antibody in Immunohistochemistry (Paraffin) (IHC (P))

Search
Proteintech
TSPY3 Polyclonal Antibody
{{$productOrderCtrl.translations['antibody.pdp.commerceCard.promotion.promotions']}}
{{$productOrderCtrl.translations['antibody.pdp.commerceCard.promotion.viewpromo']}}
{{$productOrderCtrl.translations['antibody.pdp.commerceCard.promotion.promocode']}}: {{promo.promoCode}} {{promo.promoTitle}} {{promo.promoDescription}}. {{$productOrderCtrl.translations['antibody.pdp.commerceCard.promotion.learnmore']}}
产品信息
22257-1-AP
种属反应
宿主/亚型
分类
类型
抗原
偶联物
形式
浓度
规格
纯化类型
保存液
内含物
保存条件
运输条件
产品详细信息
Immunogen sequence: MRPEGSLTY RVPERLRQGF CGVGRAAQAL VCASAKEGTA FRMEAVQEGA AGVESEQAAL GEEAVLLLDD IMAEVEVVAE EEGLVERREE AQRAQQAVPG PGPMTPESAL EELLAVQVEL EPVNAQARKA FSRQREKMER RRKPQLDRRG AVIQSVPGFW ANVIANHPQM SALITDEDED MLSYMVSLEV EEEKHPVHLC KIMLFFRSNP YFQNKVITKE YLVNITEYRA SHSTPIEWYP DYEVEAYRRR HHNSSLNFFN WFSDHNFAGS NKIAEILCKD LWRNPLQYYK RMKPPEEGTE TSGDSQLLS (1-308 aa encoded by BC075016 )
靶标信息
TSPY3 (Testis Specific Protein Y-Linked 3) is a Protein Coding gene. An important paralog of this gene is TSPY4. [GeneCards]
仅用于科研。不用于诊断过程。未经明确授权不得转售。
篇参考文献 (0)
生物信息学
蛋白别名: Cancer/testis antigen 78; CT78; Testis-specific Y-encoded protein 1; Testis-specific Y-encoded protein 10; Testis-specific Y-encoded protein 3
基因别名: CT78; TSPY; TSPY1; TSPY10; TSPY3
UniProt ID: (Human) Q01534
Entrez Gene ID: (Human) 728137